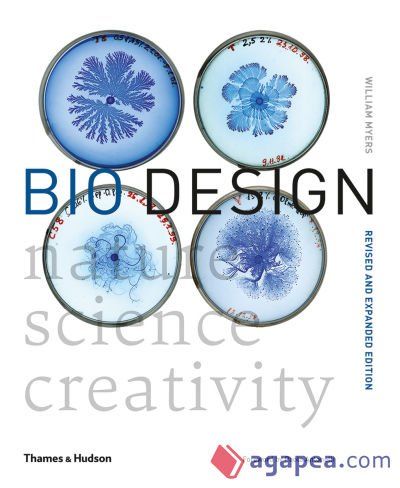
Bio Design

ELIGE TUS LIBROS ¡EL ENVÍO ES GRATIS!*
* Envíos a partir de 18€ para España peninsular, Tenerife, Gran Canaria y Mallorca
Detalles del libro
| Editorial | Thames and Hudson Ltd |
|---|---|
| Edición | (2018) | Páginas | 304 |
| Idioma | Inglés |
| ISBN | 9780500294390 |
| ISBN-10 | 0500294399 |
Detalles del libro
| Autor/es | William Myers |
|---|---|
| Editorial | Thames and Hudson Ltd |
| Edición | (2018) | Páginas | 304 |
| Idioma | Inglés |
| ISBN | 9780500294390 |
| ISBN-10 | 0500294399 |
Otra información de interés
- Portada: Bio Design de Thames and Hudson Ltd
- Editorial: Thames and Hudson Ltd | 2018
- Sinopsis:
El autor de Bio Design, con isbn 978-0-500-29439-0, es William Myers, esta publicación tiene trescientas cuatro páginas.

Resumen
Otros libros de William Myers son Drift. Choreographing The Future, An Old Roman Catholic Catechism, Bio Art: Altered Realities, Fighters, Bombers, Tanks, Wolves: Gitchigumi, Welcome To Blackwater, Old Roman Catholic Ritual, Old Roman Catholicism y Old Roman Catholic Pew Missal. Ver su bibliografía.